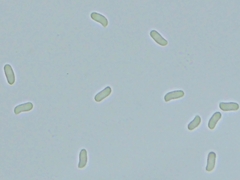
Peniophora incarnata

Peniophora incarnata: taxon details and analytics
- Domain
- Kingdom
- Fungi
- Phylum
- Basidiomycota
- Class
- Agaricomycetes
- Order
- Russulales
- Family
- Peniophoraceae
- Genus
- Peniophora
- Species
- Peniophora incarnata
- Scientific Name
- Peniophora incarnata
Summary description from Wikipedia:
Peniophora incarnata
Peniophora incarnata, the rosy crust fungus, is a species of Basidiomycotal fungus in the order Russulales and family Peniophoraceae. It is a resupinate, or crust-like species, that grows on the surface of bark. In Scandinavia it grows on a range of deciduous hosts and less often on coniferous trees.
...Peniophora incarnata in languages:
- Bokmål
- rødt torneskinn
- Czech
- kornatka masová
- Danish
- Laksefarvet voksskind
- Dutch
- Oranjerode korstzwam
- Dutch
- Oranjerode schorszwam
- English
- Rosy Crust
- Finnish
- lohiorvakka
- German
- Fleischroter Zystidenrindenpilz
- Hungarian
- élénkszínű terülőgomba
- Lithuanian
- Rausvoji vaškuotė
- Russian
- Пениофора мясо-красная
- Swedish
- tätskinn
Images from inaturalist.org observations:
We recommend you sign up for this excellent, free service.
Parent Taxon
Sibling Taxa
- Peniophora albobadia
- Peniophora aspera
- Peniophora aurantiaca
- Peniophora boidinii
- Peniophora carnea
- Peniophora cinerea
- Peniophora coprosmae
- Peniophora crustosa
- Peniophora decorticans
- Peniophora ericina
- Peniophora erikssonii
- Peniophora incarnata
- Peniophora junipericola
- Peniophora laeta
- Peniophora laurentii
- Peniophora lilacea
- Peniophora limitata
- Peniophora lycii
- Peniophora malenconii
- Peniophora meridionalis
- Peniophora metuloidea
- Peniophora nuda
- Peniophora odorata
- Peniophora piceae
- Peniophora pini
- Peniophora pithya
- Peniophora polygonia
- Peniophora proxima
- Peniophora pruinata
- Peniophora pseudopini
- Peniophora pseudoversicolor
- Peniophora quercina
- Peniophora rufa
- Peniophora rufomarginata
- Peniophora scintillans
- Peniophora septentrionalis
- Peniophora subacida
- Peniophora tamaricicola
- Peniophora thujae
- Peniophora violaceolivida